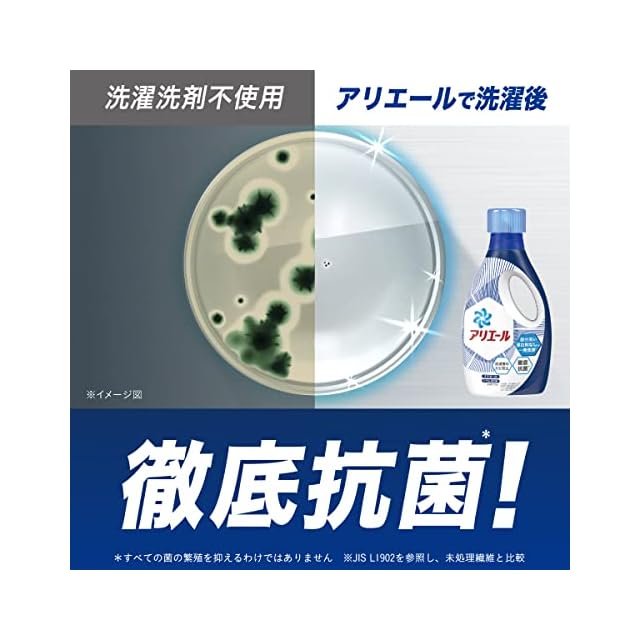

1/7
【まとめ買い】 アリエール バイオサイエンス 洗濯洗剤 液体 抗菌&菌のエサまで除去 詰め替え 超ウルトラジャンボ 約2.8倍 (1900g) × 2個
¥5,826
International shipping available
【商品概要】
科学と自然の力で大改良アリエールバイオサイエンス。科学の洗浄力と自然の分解力で洗浄力の限界突破*。落ちにくいえりソデ汚れもしっかり落とします。*P&G従来品比較
独自の抗菌成分配合で干している間、着用中も徹底抗菌* *すべての菌の増殖を抑えるわけではありません。
洗濯槽クリーナーなしでも洗濯槽のカビ対策OK! 洗濯槽の防カビもできます。
自然からヒントを得た抗酸化成分配合で、今までごまかしていた枕カバーや加齢臭といったニオイも発生から防ぎます。
液だれ防止キャップなので、あの嫌な液だれもしっかり防ぎます。
【商品詳細】
ブランド:アリエール
商品種別:液体洗剤
商品名:【まとめ買い】 アリエール バイオサイエンス 洗濯洗剤 液体 抗菌&菌のエサまで除去 詰め替え 超ウルトラジャンボ 約2.8倍 (1900g) × 2個
製造元:P&G
商品番号:4987176044709
発売日:2021年11月13日
商品内容:1本 (x 20)
梱包サイズ:68.7cm
-
レビュー
(84)
最近チェックした商品
その他の商品